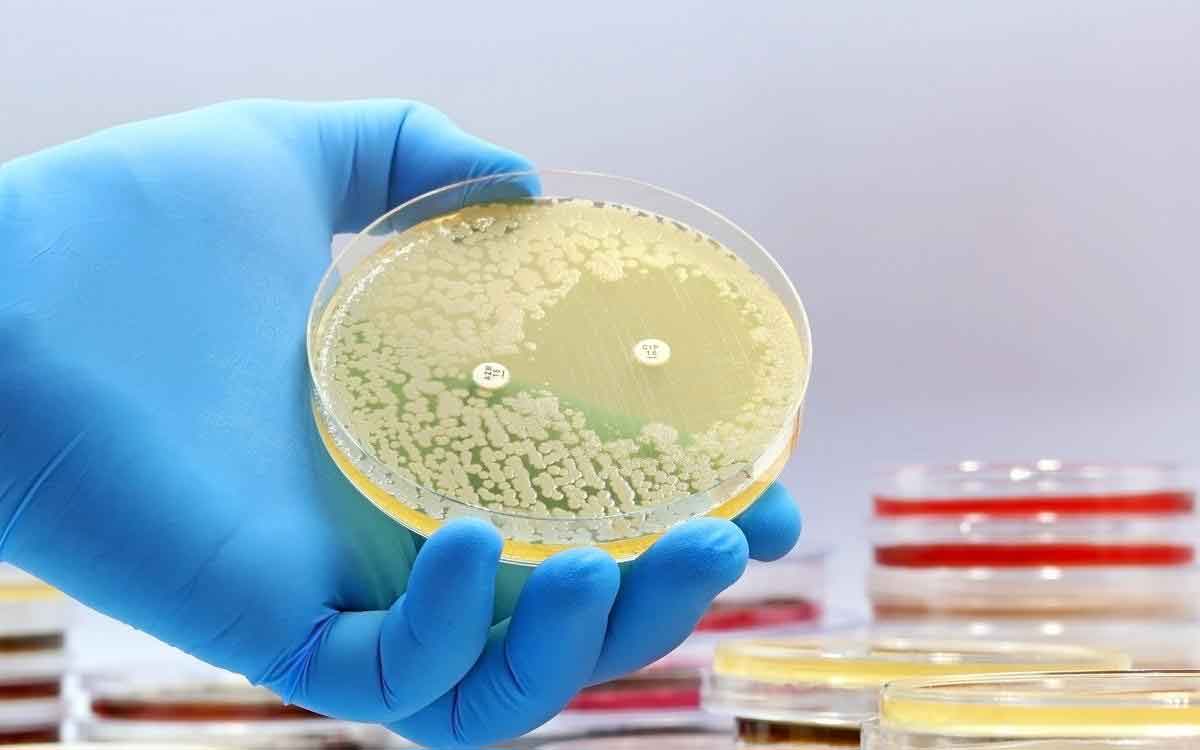
Superbugs | డ్రైనేజీ వ్య‌వ‌స్థ‌ల్లో వృద్ధి చెందుతున్న సూప‌ర్ బ‌గ్స్.. ఏంటివి.. వీటితో వ‌చ్చే ప్ర‌మాదం ఏమిటి..?

Superbugs | భారతదేశంలోని పట్టణాల్లో ఉన్న డ్రైనేజ్ వ్యవస్థలు (Urban drainage systems) ప్రపంచంలో పెరుగుతున్న పెద్ద ఆరోగ్య సమస్య అయిన యాంటీ మైక్రోబియల్ రెసిస్టెన్స్ (AMR) ను పెంచుతున్నాయని కొత్త పరిశోధనలు చెబుతున్నాయి. తాజా అధ్యయనం ప్రకారం, భారత నగరాల డ్రైనేజీల్లో ప్రవహించే మురుగునీటిలో బ్యాక్టీరియా, యాంటీబయోటిక్ అవశేషాలు, రెసిస్టెన్స్ జీన్లు కలిసిన సంక్లిష్ట మిశ్రమం ఉంది. ఇవి కలిసి మందులకు పనిచేయని సూపర్బగ్స్ (Superbugs) తయారయ్యేందుకు అనుకూల పరిస్థితులను సృష్టిస్తున్నాయని నిపుణులు చెబుతున్నారు. ఈ అధ్యయనాన్ని BRIC-ట్రాన్స్లేషనల్ హెల్త్ సైన్స్ అండ్ టెక్నాలజీ ఇన్స్టిట్యూట్ (THSTI), కేంబ్రిడ్జ్ యూనివర్సిటీ, కోల్కతా యూనివర్సిటీ, NIPER గువాహటి సంస్థల పరిశోధకులు నిర్వహించారు. ఈ పరిశోధనలో ముఖ్యంగా నగరాల డ్రైనేజీల్లో యాంటీ బయోటిక్ రెసిస్టెన్స్ జీన్లు పెద్ద సంఖ్యలో ఉన్నాయని, అలాగే హాస్పిటల్ ఇన్ఫెక్షన్లకు కారణమయ్యే బ్యాక్టీరియాకు దగ్గరగా ఉండే సూక్ష్మజీవులు కూడా ఉన్నాయని తేలింది. నిపుణుల ప్రకారం, ఇది యాంటీ మైక్రోబియల్ రెసిస్టెన్స్కు పర్యావరణం కూడా పెద్ద కారణమవుతుందని చూపిస్తోంది. హాస్పిటల్స్, ఇళ్లలో, వ్యవసాయంలో, ఔషధ తయారీ పరిశ్రమల్లో ఉపయోగించే యాంటీ బయోటిక్స్ చివరికి మానవ మలమూత్రం లేదా శుద్ధి చేయని వ్యర్థాల ద్వారా డ్రైనేజీల్లోకి చేరుతాయి. ఈ కలుషిత వాతావరణంలో బ్యాక్టీరియా తక్కువ మోతాదులో మందులకు పదే పదే గురవుతూ, వాటికి ప్రతిఘటన కలిగేలా మార్పులు చెందుతాయి. ప్రపంచ ఆరోగ్య సంస్థలు ఇప్పటికే AMR ను ఆధునిక వైద్యానికి పెద్ద ప్రమాదంగా గుర్తించాయి. అలాంటి పరిస్థితుల్లో పట్టణ మురుగునీరు సూపర్బగ్స్ పెరిగే కేంద్రంగా మారుతున్నదనే విషయం ప్రజారోగ్యానికి ఆందోళన కలిగిస్తోంది.
ఇక బ్యాక్టీరియా మందులు చంపలేని విధంగా మార్పులు చెందితే దానిని యాంటీ బయోటిక్ రెసిస్టెన్స్ అంటారు. ఇలాంటి బ్యాక్టీరియాను సాధారణంగా సూపర్బగ్స్ అని పిలుస్తారు, ఎందుకంటే వీటి వల్ల వచ్చే ఇన్ఫెక్షన్లకు చికిత్స చేయడం చాలా కష్టంగా ఉంటుంది.ఉదాహరణకు NDM-1 (New Delhi metallo-beta-lactamase-1) అనే జీన్ కలిగిన బ్యాక్టీరియా. ఈ జీన్ ఉన్న సూక్ష్మజీవులు కార్బపెనెమ్స్ వంటి బలమైన యాంటీ బయోటిక్స్కి కూడా ప్రతిఘటన చూపుతాయి. ఇవి సాధారణంగా తీవ్రమైన ఇన్ఫెక్షన్లకు చివరి దశ చికిత్సగా ఉపయోగించే మందులు. ఈ సూపర్బగ్స్ కారణంగా హాస్పిటల్లో ఎక్కువ రోజులు ఉండాల్సి రావచ్చు. చికిత్స ఖర్చులు కూడా పెరుగుతాయి. మరణాల ప్రమాదం కూడా ఎక్కువయ్యే అవకాశం ఉంది. ప్రపంచ ఆరోగ్య అంచనాల ప్రకారం, యాంటీ మైక్రోబియల్ రెసిస్టెన్స్ ఇప్పటికే ప్రతి సంవత్సరం లక్షలాది మరణాలకు కారణమవుతోంది.
పరిశోధకుల ప్రకారం, భారత నగరాల డ్రైనేజీలు బ్యాక్టీరియా రెసిస్టెన్స్ పెరగడానికి అనుకూలమైన వాతావరణంగా ఉన్నాయి. శుద్ధి చేయని గృహ మురుగునీరు, యాంటీ బయోటిక్ అవశేషాలు ఉన్న హాస్పిటల్ వ్యర్థాలు, ఔషధ తయారీ పరిశ్రమల వ్యర్థాలు, వ్యవసాయ నీటి ప్రవాహం, పారిశ్రామిక రసాయనాలు వంటి పదార్థాలు కలిసి మురుగునీటిలో బ్యాక్టీరియాను తక్కువ మోతాదులో యాంటీ బయోటిక్స్కు గురి చేస్తాయి. ఇది బ్యాక్టీరియాను చంపకుండా, వాటిని మందులకు తట్టుకునేలా పరిణామం చెందేలా చేస్తుంది. ఈ కారణం వల్లనే శాస్త్రవేత్తలు మురుగునీటి వాతావరణాన్ని జెనెటిక్ ప్లేగ్రౌండ్ అని పిలుస్తున్నారు. ఎందుకంటే అక్కడ ఉన్న బ్యాక్టీరియా హారిజాంటల్ జీన్ ట్రాన్స్ఫర్ అనే ప్రక్రియ ద్వారా ఒకదానితో ఒకటి రెసిస్టెన్స్ జీన్లు పంచుకుంటాయి. ఈ పరిశోధనలో 170కి పైగా యాంటీ బయోటిక్ రెసిస్టెన్స్ జీన్లు గుర్తించబడ్డాయి. వీటిలో చాలా వరకు హాస్పిటల్ ఇన్ఫెక్షన్లకు కారణమయ్యే పాథోజెన్స్తో సంబంధం ఉన్నవే.
భారతదేశంలోని పలు నగరాల్లో కూడా ఈ సమస్యకు ఆధారాలు లభించాయి. హైదరాబాద్లో చేసిన ఒక అధ్యయనం ప్రకారం ఓపెన్ డ్రైన్స్, నదులు, సరస్సుల్లో 89 రకాల పాథోజెన్స్ రెసిస్టెన్స్ జీన్లతో గుర్తించబడ్డాయి. ఇవి గృహాలు, వ్యవసాయం, హాస్పిటల్స్ నుంచి వచ్చే శుద్ధి చేయని మురుగునీటి కారణంగా మనుషులు, జంతువులు, పర్యావరణ సూక్ష్మజీవులు కలిసిపోతున్నాయని తెలియజేస్తుంది. అలాగే ఉత్తరాఖండ్లోని పట్టణ డ్రైనేజీల్లో కూడా యాంటీ బయోటిక్ రెసిస్టెంట్ బ్యాక్టీరియా పెద్ద సంఖ్యలో ఉన్నట్లు పరిశోధనలు తెలిపాయి. ఈ సూక్ష్మజీవులు చివరికి నేల, భూగర్భ జలం, ఆహార వ్యవస్థలోకి చేరే ప్రమాదం ఉందని పరిశోధకులు హెచ్చరిస్తున్నారు.
అలాగే ఈ పరిశోధన ఒక ముఖ్యమైన విషయాన్ని కూడా చూపిస్తోంది. యాంటీ మైక్రోబియల్ రెసిస్టెన్స్ కేవలం హాస్పిటల్ సమస్య మాత్రమే కాదు, ఇది పర్యావరణ సమస్య కూడా. భారతదేశంలో చాలా ప్రాంతాల్లో సరైన పారిశుద్ధ్య వ్యవస్థలు లేవు. మురుగునీటి శుద్ధి తగినంతగా జరగదు. దీంతో శుద్ధి చేయని మురుగునీరు నదులు, నీటి వనరుల్లోకి చేరుతుంది. ఈ నీటిని వ్యవసాయం, తాగునీరు, వినోద కార్యక్రమాలు వంటి పనుల కోసం ఉపయోగించే అవకాశం ఉంది. దీంతో మనుషుల్లోకి రెసిస్టెంట్ బ్యాక్టీరియా చేరే ప్రమాదం పెరుగుతుంది. అదే విధంగా యాంటీ బయోటిక్ రెసిస్టెన్స్ అనే ఈ సమస్య ఒక చక్రంలా కొనసాగుతుంది. ఆరోగ్య సంరక్షణ లేదా వ్యవసాయంలో యాంటీబయోటిక్స్ ను వాడుతారు. దీంతో మందుల అవశేషాలు మురుగునీటిలోకి చేరుతాయి. డ్రైనేజీల్లో బ్యాక్టీరియా రెసిస్టెంట్ అభివృద్ది చెందుతుంది. ఈ బ్యాక్టీరియా తిరిగి మనుషులలోకి చేరుతాయి. ఈ చక్రాన్ని విరమించడానికి మెరుగైన పర్యవేక్షణ, వ్యర్థ నిర్వహణ అవసరమని నిపుణులు తెలియజేస్తున్నారు.
ప్రజారోగ్య నిపుణులు వన్ హెల్త్ (One Health) విధానం అవసరమని చెబుతున్నారు. ఇది మనుషులు, జంతువులు, పర్యావరణ ఆరోగ్యాన్ని కలిపి చూసేటువంటి ఒక విధానం. వేస్ట్వాటర్ ట్రీట్మెంట్ సదుపాయాలను పెంచాలి. AMR జీన్లను గుర్తించడానికి మురుగునీటిని పరిశీలించడం ముందస్తు హెచ్చరికగా ఉపయోగపడుతుంది. హెల్త్కేర్, వ్యవసాయంలో అవసరం లేని యాంటీ బయోటిక్ వినియోగాన్ని తగ్గించాలి. ఫార్మాసూటికల్, హాస్పిటల్ వ్యర్థాలను నియంత్రించడం వంటి ముఖ్యమైన చర్యలను నివారణ మార్గాలుగా నిపుణులు సూచిస్తున్నారు. భారతదేశంలోని పట్టణ డ్రైనేజీలు సూపర్బగ్స్ తయారయ్యే ప్రయోగశాలలుగా మారుతున్నాయనే విషయాన్ని ఈ పరిశోధన స్పష్టం చేసింది. డ్రగ్-రెసిస్టెంట్ ఇన్ఫెక్షన్లపై పోరాటం కేవలం హాస్పిటల్స్లోనే కాదు, పర్యావరణంలో కూడా జరగాల్సిన అవసరం ఉందని తాజా అధ్యయనం చెబుతోంది. శుద్ధి చేయని మురుగునీరు, యాంటీ బయోటిక్ అవశేషాలు, తగిన పారిశుద్ధ్య వ్యవస్థల లేమి వల్ల బ్యాక్టీరియా ఆధునిక వైద్యం కంటే వేగంగా పరిణామం చెందే పరిస్థితులు ఏర్పడుతున్నాయి. కనుక ఈ సమస్యలను త్వరగా ఎదుర్కోవడం ద్వారా భవిష్యత్తులో చికిత్స చేయలేని ఇన్ఫెక్షన్ల ప్రమాదాన్ని తగ్గించవచ్చు.